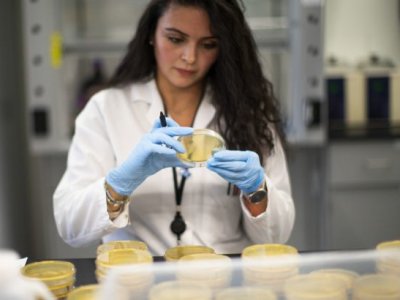

Вчені стверджують, що вони виявили “прихований” варіант штаму коронавірусу “Омікрон”. За їх словами, його неможливо відрізнити від інших штамів за допомогою ПЛР-тестів, які використовуються співробітниками охорони здоров’я для отримання швидкої картини поширення коронавірусу по всьому світу.

Про це повідомляє РБК-Україна з посиланням на The Guardian .
Цей варіант, як і раніше, визначається як коронавірус за допомогою всіх звичайних тестів, і може бути ідентифікований як штам “Омікрон” за допомогою геномного тестування, але ймовірні випадки не будуть виявлені за допомогою звичайних тестів ПЛР, які дають більш швидкі результати.
Дослідники кажуть, що ще дуже рано судити про те, чи нова форма “Омікрону” буде поширюватися так само, як і стандартний штам, але “прихований” варіант генетично відрізняється і тому цілком може поводитися по-іншому.
Прихований варіант був вперше виявлений серед геномів COVID, представлених останніми днями з Південної Африки, Австралії та Канади, але, можливо, він уже поширився ширше. Серед кількох десятків випадків, виявлених на даний момент, немає жодного у Великій Британії.
Джерело: РБК-УКРАЇНА
Мітки: COVID-19, здоров'я, коронавірус, Омікрон, ПЛР-тести

6119
6119